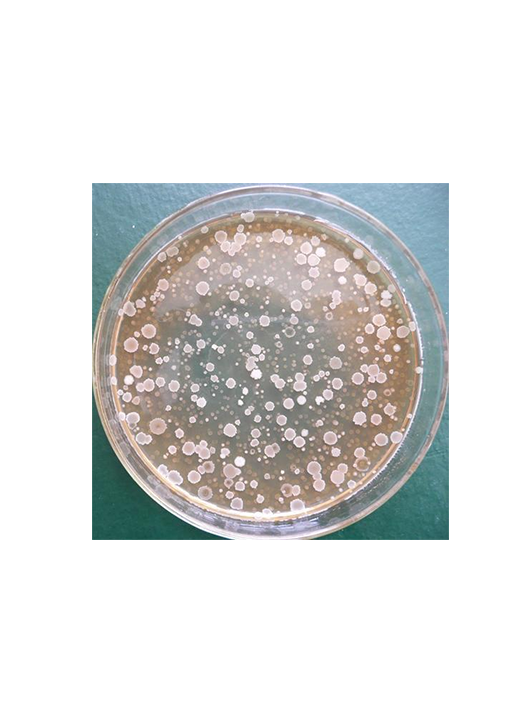
納豆芽孢桿菌

嗜熱脂肪地芽孢桿菌
嗜熱脂肪地芽孢桿菌(Bacillus stearothermophilus)���,營養(yǎng)細(xì)胞呈長桿狀、圓端��,多數(shù)為單個(gè)�、少數(shù)成對(duì)或鏈狀排列��,細(xì)胞寬0.6~1.0μm����、長2.0~3.5μm�����,細(xì)胞壁為革蘭陽性結(jié)構(gòu)���,但染色可在陽性和陰性之間變化。芽孢呈橢圓或柱狀����、端生或次端生����,孢囊膨脹或不膨脹,無伴孢晶體形成�����。最佳生長溫度為56~60℃�,最高生長溫度為65~75℃���,需氧或兼性厭氧。
需氧或兼性厭氧
耐熱性強(qiáng)